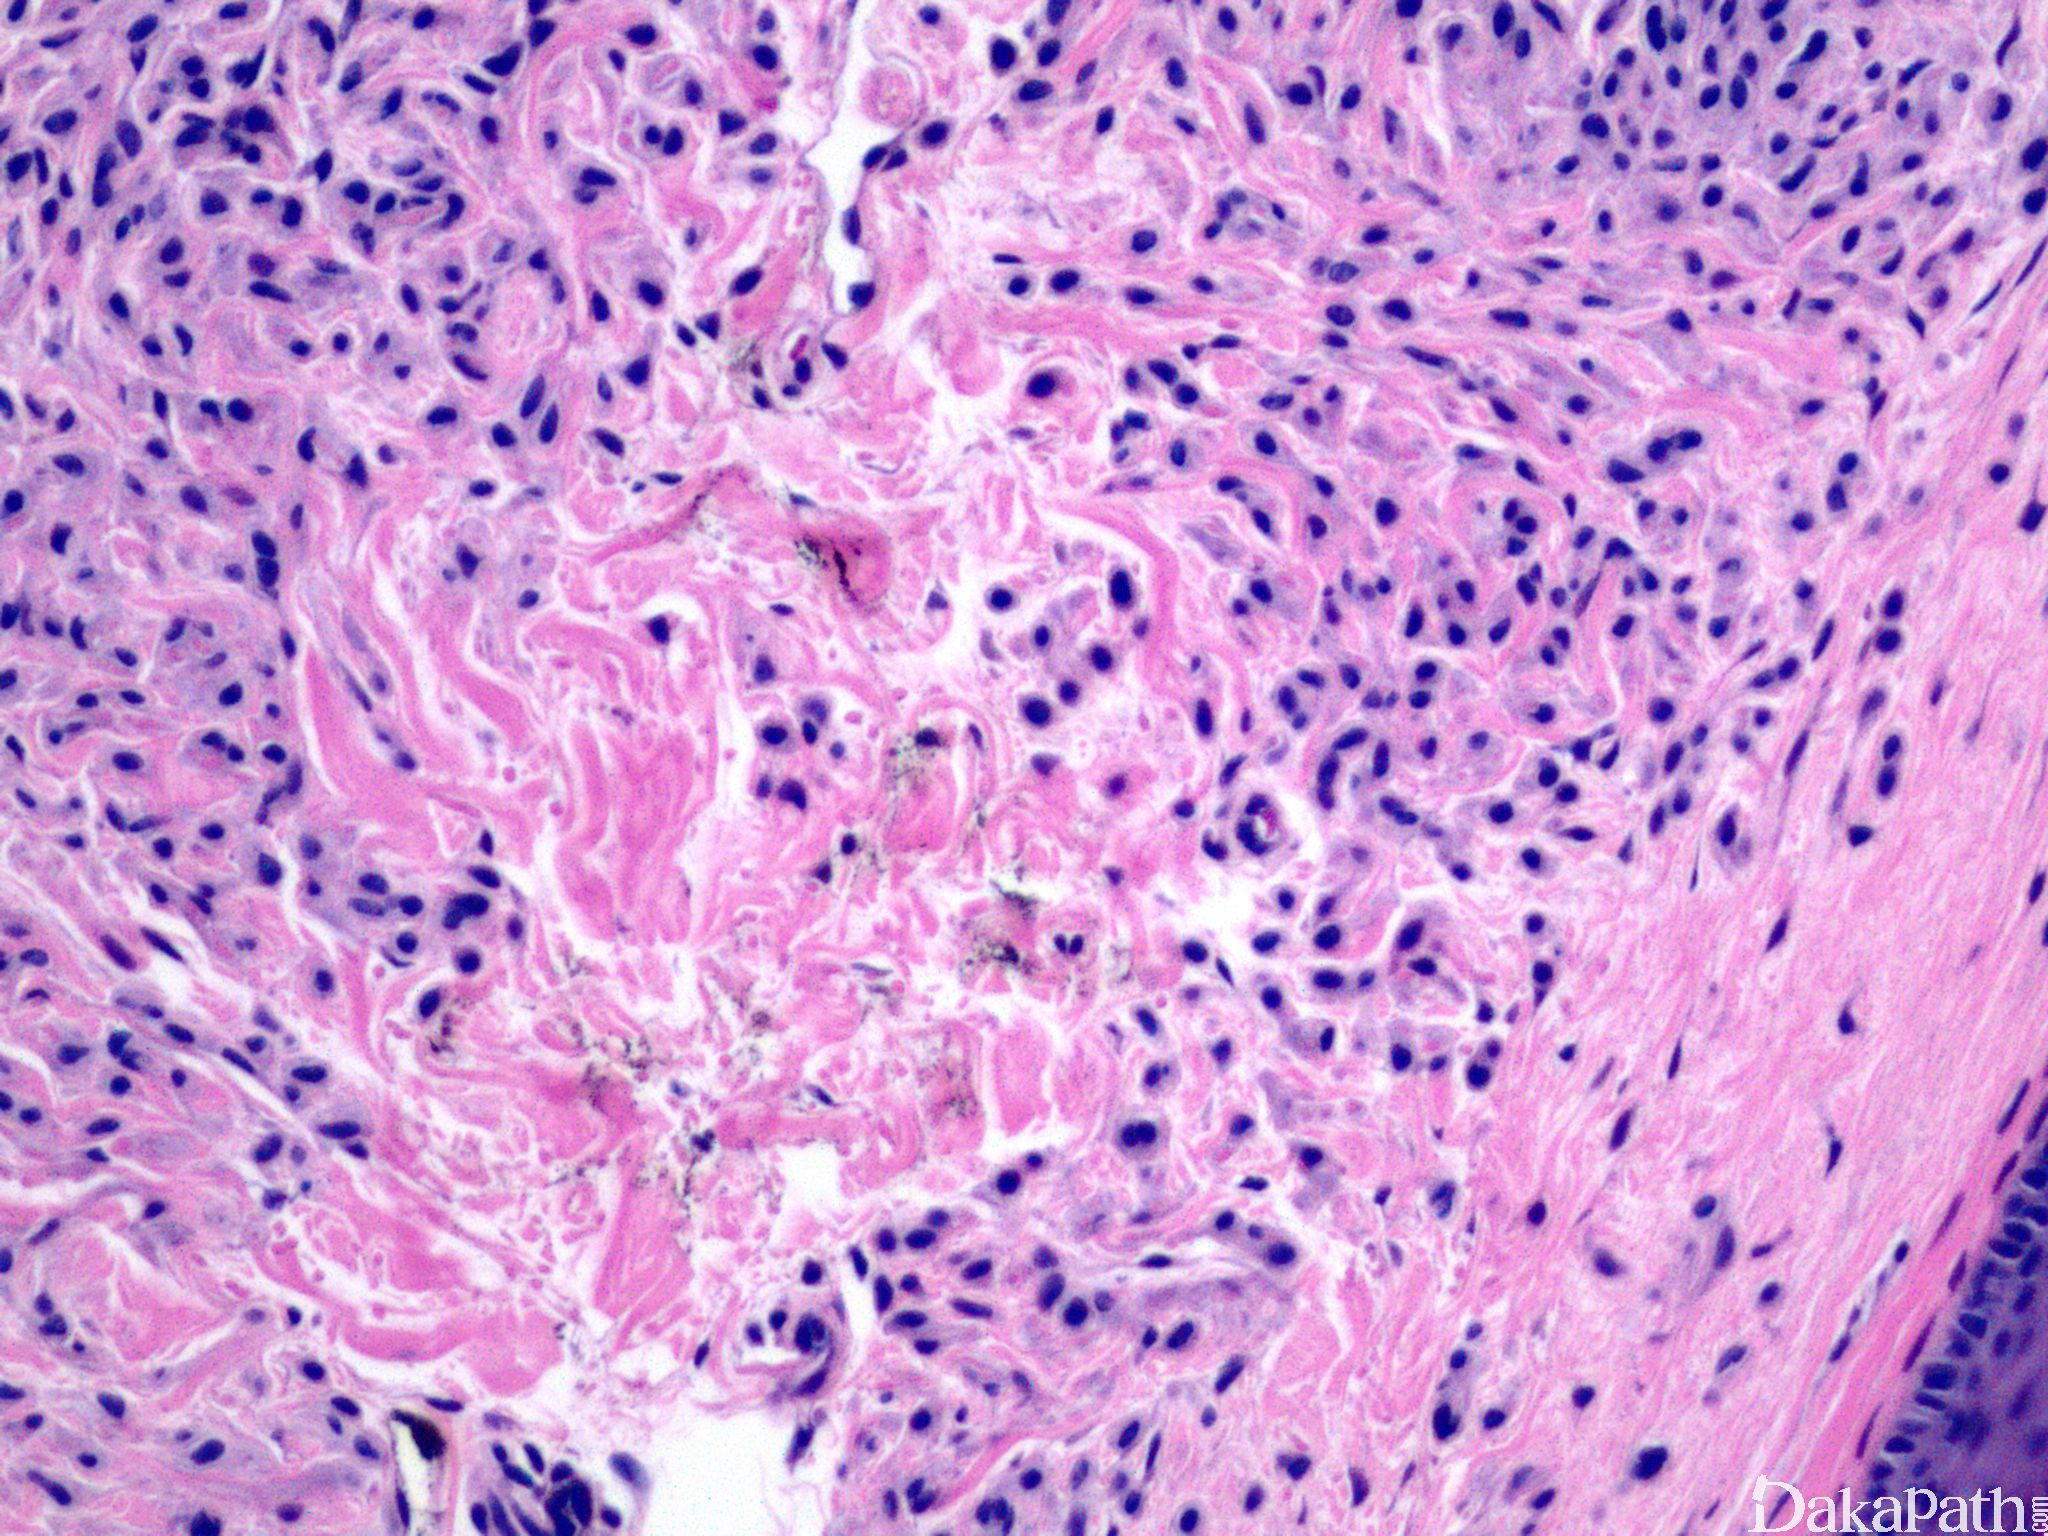

复合痣
Compound Nevus
概述:
同时具有交界痣和皮内痣两种形态特征。
诊断要点:
主要见于青年,隆起或呈穹窿形,色较交界痣为浅;
同时具有交界痣和皮内痣两种形态;
交界痣成分类似于交界痣,无 Paget 样扩张,对称性生长,无细胞异型性及核分裂像,随着年龄增加,交界痣成分逐步较少;
皮内痣成分包括巢状或线性排列的痣细胞,细胞小,浆少,核规则,从浅表到基底有逐步成熟现象,细胞逐渐变细或呈梭形,色素减少;
真皮内细胞巢被纤维组织分隔;
基底常见成簇淋巴细胞浸润;
个别病例伴黏液变性;
偶尔可见核分裂像,无病理性核分裂像。